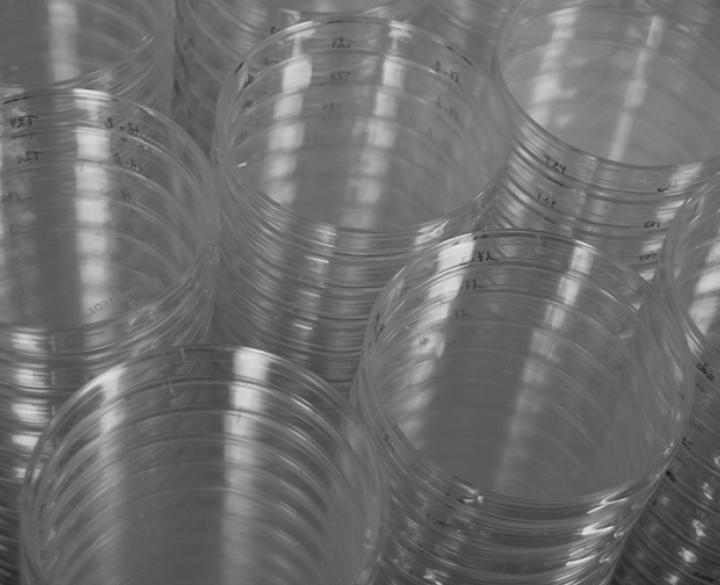
petri dishes

Hygiene, barrier properties and health related aspects of textiles
Contact form
The form below enables you to submit your question or price enquiry about tests performed by the microbiology lab. For questions destined to our other labs, please go to the dedicated page (accessible by clicking on "Testing" in the menu above).